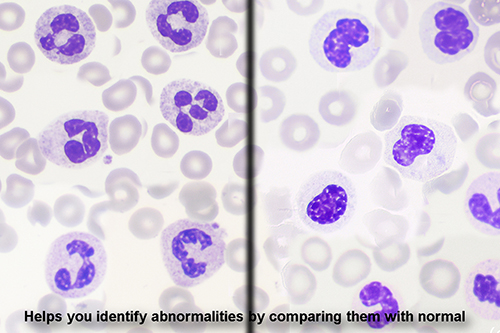
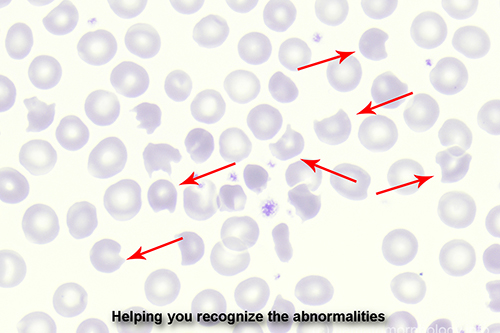
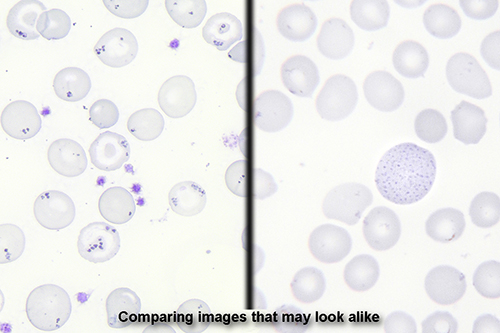
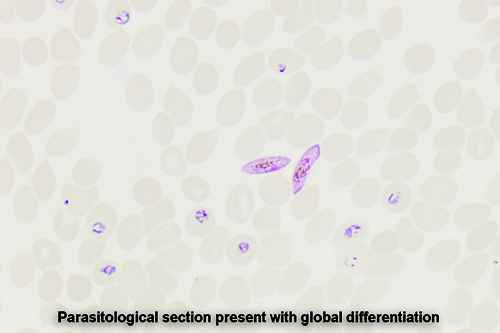

and those with special interest in hemato-morphology.
All images presented here are in high resolution, best viewed on a calibrated monitor.
If you encounter difficulty displaying pages, use the CTRL key in combination with the mouse wheel to adjust the display.
This imagebank database (with over 2,400 images) will be updated on a regular base.
Take your tour in the DEMO pages now
See the following pages for more information about the membership or pricing, or fill in the contact form now
You can use the menu on top to navigate or use the search engine.
I am Lex Scholten, senior technician hematomorphology & immunophenotyping @ CWZ (Canisius Wilhelmina Hospital), Netherlands.
Some of the images are from cases kindly provided by Deventer Ziekenhuis and Certe medical diagnostic, Netherlands.